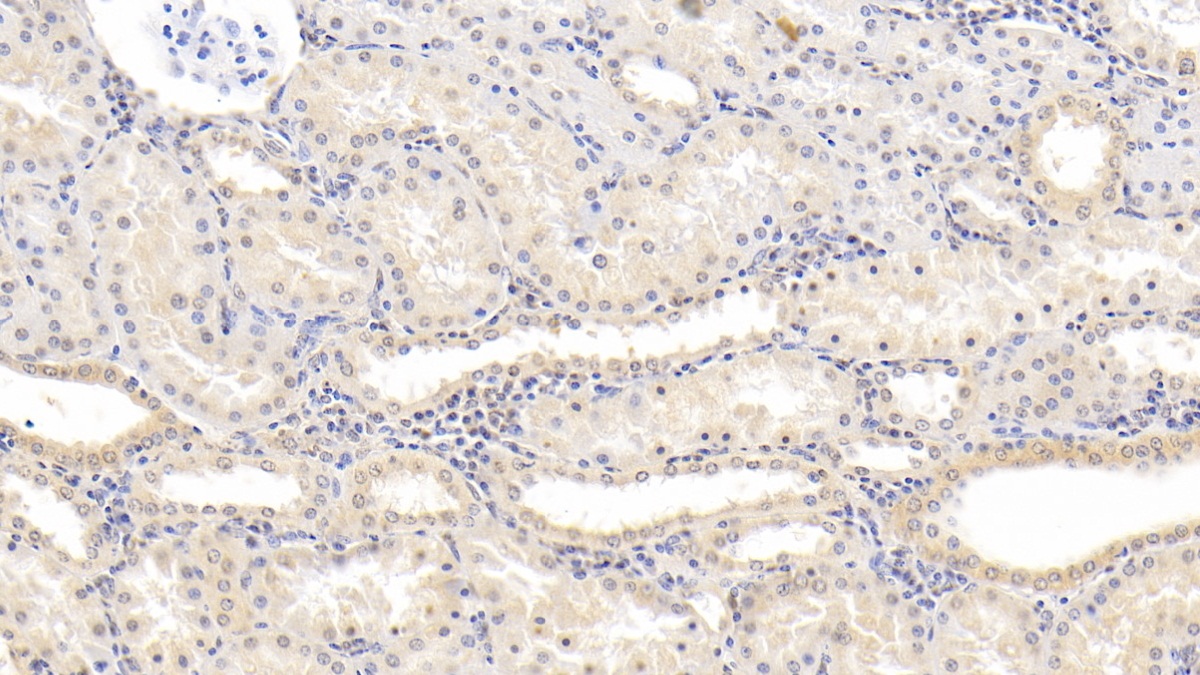

Monoclonal Antibody to Neurotrophin 3 (NT3)
NTF3; HDNF; NGF2; Nerve Growth Factor 2; Neurotrophic Factor
- Product No.MAA106Hu24
- Organism SpeciesHomo sapiens (Human) Same name, Different species.
- SourceMonoclonal antibody preparation
- HostMouse
- Potency (Clone Number)D3
- Ig Isotype IgG1 Kappa
- PurificationProtein A + Protein G affinity chromatography
- LabelNone
- Immunogen RPA106Hu02-Recombinant Neurotrophin 3 (NT3)
- Buffer Formulation0.01M PBS, pH7.4, containing 0.05% Proclin-300, 50% glycerol.
- TraitsLiquid
- Concentration1mg/ml
- Organism Species Moren/a
- ApplicationsIHC; ICC/IF
If the antibody is used in flow cytometry, please check FCM antibodies. - DownloadInstruction Manual
- UOM 20µl100µl 200µl 1ml 10ml
- FOB
US$ 104
US$ 243
US$ 347
US$ 868
US$ 3470
For more details, please contact local distributors!
SPECIFITY
The antibody is a mouse monoclonal antibody raised against NT3. It has been selected for its ability to recognize NT3 in immunohistochemical staining and western blotting.
USAGE
Western blotting: 0.5-2µg/mL;
Immunohistochemistry: 5-30µg/mL;
Immunocytochemistry: 5-30µg/mL;
Optimal working dilutions must be determined by end user.
STORAGE
Store at 4°C for frequent use. Stored at -20°C in a manual defrost freezer for two year without detectable loss of activity. Avoid repeated freeze-thaw cycles.
STABILITY
The thermal stability is described by the loss rate. The loss rate was determined by accelerated thermal degradation test, that is, incubate the protein at 37°C for 48h, and no obvious degradation and precipitation were observed. The loss rate is less than 5% within the expiration date under appropriate storage condition.
GIVEAWAYS
INCREMENT SERVICES
-
 Antibody Labeling Customized Service
Antibody Labeling Customized Service
-
 Protein A/G Purification Column
Protein A/G Purification Column
-
 Staining Solution for Cells and Tissue
Staining Solution for Cells and Tissue
-
 Positive Control for Antibody
Positive Control for Antibody
-
 Tissue/Sections Customized Service
Tissue/Sections Customized Service
-
 Phosphorylated Antibody Customized Service
Phosphorylated Antibody Customized Service
-
 Western Blot (WB) Experiment Service
Western Blot (WB) Experiment Service
-
 Immunohistochemistry (IHC) Experiment Service
Immunohistochemistry (IHC) Experiment Service
-
 Immunocytochemistry (ICC) Experiment Service
Immunocytochemistry (ICC) Experiment Service
-
 Flow Cytometry (FCM) Experiment Service
Flow Cytometry (FCM) Experiment Service
-
 Immunoprecipitation (IP) Experiment Service
Immunoprecipitation (IP) Experiment Service
-
 Immunofluorescence (IF) Experiment Service
Immunofluorescence (IF) Experiment Service
-
 Buffer
Buffer
-
 DAB Chromogen Kit
DAB Chromogen Kit
-
 SABC Kit
SABC Kit
-
 Long-arm Biotin Labeling Kit
Long-arm Biotin Labeling Kit
-
 Real Time PCR Experimental Service
Real Time PCR Experimental Service
| Magazine | Citations |
| S | Caracteriza Teses: Disponiveis |
| Canadian Journal of Physiology and Pharmacology | Protective effects of telmisartan and tempol on lipopolysaccharide-induced cognitive impairment, neuroinflammation, and amyloidogenesis: possible role of brain-derived neurotrophic factor pubmed:28388365 |
| Efecto de Diferentes Intervenciones de Ejercicio Físico Agudo Sobre Niveles Plasmáticos de BDNF, NT-3 y NT-4 en Adultos con Sobrepeso : | |
| Artificial Cells Nanomedicine and Biotechnology | Histological and functional outcomes in a rat model of hemisected spinal cord with sustained VEGF/NT-3 release from tissue-engineered grafts Pubmed: 31899965 |
| laboratory investigation | Macrophage-derived neurotrophin-3 promotes heterotopic ossification in rats Pubmed: 31896816 |
| EUROPEAN CHILD & ADOLESCENT PSYCHIATRY | Increased serum brain-derived neurotrophic factor and adrenocorticotropic hormone levels are associated with obsessive compulsive disorder in medication?free?¡ 33389158 |
| BIOSCIENCE BIOTECHNOLOGY AND BIOCHEMISTRY | Sea urchin gangliosides exhibit neuritogenic effects in neuronal PC12 cells via TrkA- and TrkB-related pathways 33589896 |
| Clin Epigenetics | Genome?wide profiling of DNA methylation and gene expression unravel the epigenetic landscape in diabetes-related hypothyroidism 34092241 |
| J Nutr Sci Vitaminol (Tokyo) | Effects of a Tea Cultivar “MK5601” on Behaviors and Hippocampal Neurotrophin-3 Levels in Middle-Aged Mice 34193676 |
| Iranian Journal of Basic Medical Sciences | Adrenomedullin increases cAMP accumulation and BDNF expression in rat DRG and spinal motor neurons 34712429 |
| Molecular Biology Reports | Umbilical cord-derived mesenchymal stem cell conditioned medium reverses neuronal oxidative injury by inhibition of TRPM2 activation and the JNK signaling … Pubmed:35585377 |
| Catalog No. | Related products for research use of Homo sapiens (Human) Organism species | Applications (RESEARCH USE ONLY!) |
| RPA106Hu01 | Recombinant Neurotrophin 3 (NT3) | Positive Control; Immunogen; SDS-PAGE; WB. |
| RPA106Hu02 | Recombinant Neurotrophin 3 (NT3) | Positive Control; Immunogen; SDS-PAGE; WB. |
| PAA106Hu02 | Polyclonal Antibody to Neurotrophin 3 (NT3) | IHC |
| PAA106Hu01 | Polyclonal Antibody to Neurotrophin 3 (NT3) | WB; IHC |
| LAA106Hu71 | Biotin-Linked Polyclonal Antibody to Neurotrophin 3 (NT3) | WB |
| MAA106Hu22 | Monoclonal Antibody to Neurotrophin 3 (NT3) | IHC |
| MAA106Hu21 | Monoclonal Antibody to Neurotrophin 3 (NT3) | IHC |
| MAA106Hu23 | Monoclonal Antibody to Neurotrophin 3 (NT3) | IHC |
| MAA106Hu24 | Monoclonal Antibody to Neurotrophin 3 (NT3) | IHC; ICC/IF |
| SEA106Hu | ELISA Kit for Neurotrophin 3 (NT3) | Enzyme-linked immunosorbent assay for Antigen Detection. |
| SCA106Hu | CLIA Kit for Neurotrophin 3 (NT3) | Chemiluminescent immunoassay for Antigen Detection. |
| LMA106Hu | Multiplex Assay Kit for Neurotrophin 3 (NT3) ,etc. by FLIA (Flow Luminescence Immunoassay) | FLIA Kit for Antigen Detection. |
| KSA106Hu01 | ELISA Kit DIY Materials for Neurotrophin 3 (NT3) | Main materials for "Do It (ELISA Kit) Yourself". |